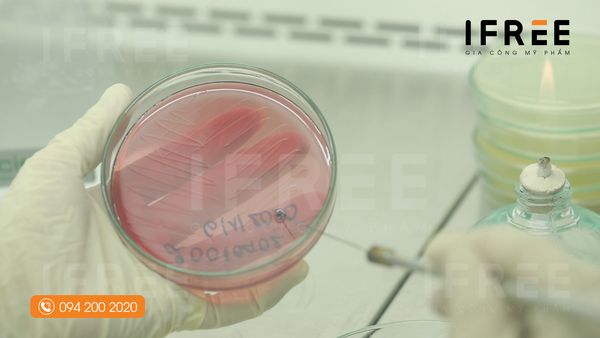
kiểm soát vi sinh trong mỹ phẩm

Tin tức gia công
Tin tức về gia công mỹ phẩm được tổng hợp hoặc tự viết bởi IFREE.
Tin tức mới nhất
[GIẢI ĐÁP] Kinh doanh mỹ phẩm cần bao nhiêu vốn là đủ?
Khi bắt đầu bước vào lĩnh vực kinh doanh nguồn vốn chính là điều được [...]
Top 11+ máy móc sản xuất mỹ phẩm quan trọng nhất
Máy sản xuất mỹ phẩm đảm nhận vai trò quan trọng quyết định chất lượng [...]
Lưu ý khi chuyển công thức gia công mỹ phẩm và nguyên liệu
Hôm nay sẽ là bài viết dành cho những khách hàng muốn chuyển công thức [...]
Hiểm họa mỹ phẩm nhiễm vi sinh – Tiêu chuẩn giới hạn quy định
Chúng ta thường nghe tới mỹ phẩm nhiễm chì, thủy ngân hay Corticoid tuy nhiên [...]
Mẫu chốt – Thủ thân khi gia công mỹ phẩm
Có khi nào Boss đi gia công mà hàng đặt với hàng mẫu khác nhau [...]
Tiêu chuẩn nhà máy mỹ phẩm: Những điều kiện bắt buộc để đạt chứng nhận cGMP
Trong bối cảnh ngành mỹ phẩm đang phát triển mạnh mẽ, hàng loạt nhà máy [...]
Thủ tục công bố mỹ phẩm – Làm giấy khai sinh cho sản phẩm
Thủ tục công bố mỹ phẩm một chủ đề rất hot mà đến 99% khách [...]
Mã số mã vạch – Dùng sao cho đúng
Với sự thật giả lẫn lộn hiện nay trên thị trường thì xu hướng quét [...]
Thời gian gia công mỹ phẩm tại nhà IFREE
Gia công mỹ phẩm là một dịch vụ mà bên đặt gia công sẽ trình bày các yêu cầu của [...]


![[GIẢI ĐÁP] Kinh doanh mỹ phẩm cần bao nhiêu vốn là đủ? 2 kinh doanh mỹ phẩm cần bao nhiêu vốn](https://ifree.vn/wp-content/uploads/2022/08/kinh-doanh-my-pham-can-gi-600x400.jpg)